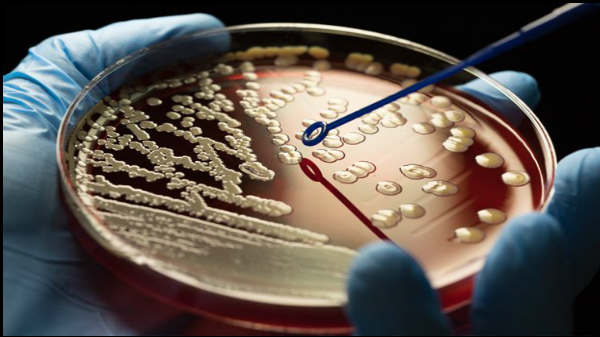
பூஞ்சைகள் மற்றும் பாக்டீரியாக்கள்

சர்வதேச விண்வெளி நிலையம் பாக்டீரியாவால் பாதிக்கப்பட்டுள்ளது.! அதிர்ச்சியில் விண்வெளி வீரர்கள்.!
சர்வதேச விண்வெளி நிலையம்(ஐ.எஸ்.எஸ்) பாக்டீரியாவால் பாதிக்கப்பட்டுள்ளது என்ற அதிர்ச்சி தகவல் தற்பொழுது வெளியாகியுள்ளது.
சர்வதேச விண்வெளி நிலையம்(ஐ.எஸ்.எஸ்) பாக்டீரியாவால் பாதிக்கப்பட்டுள்ளது என்ற அதிர்ச்சி தகவல் தற்பொழுது வெளியாகியுள்ளது.

சர்வதேச விண்வெளி நிலையம்
சர்வதேச விண்வெளி நிலையமான, ஐ.எஸ்.எஸ் இன் மையங்களில் விண்வெளி வீரர்களுக்குப் பாதிப்பு ஏற்படுத்தக்கூடிய நுண்ணுயிர்கள் கண்டுபிடிக்கப்பட்டுள்ளது. இதனால் விண்வெளி வீரர்களின் இயல்பு நிலை பாதிக்கப்பட்டு அச்சுறுத்தலான நிலைக்குக் கொண்டு செல்லும் என்று அஞ்சப்படுகிறது.

பாதுகாப்பு குறித்து நடத்தப்பட்ட ஆய்வு
நீண்டகால விண்வெளி பயணம் மற்றும் விண்வெளியில் தாங்கும் விண்வெளி வீரர்களின் பாதுகாப்பு குறித்து நடத்தப்பட்ட ஒரு ஆய்வில், இந்த அதிர்ச்சி தகவல் தெரியவந்துள்ளது.
பூஞ்சைகள் மற்றும் பாக்டீரியாக்கள்
ஐ.எஸ்.எஸ் இன் உள்ளே பல இடங்களில் நுண்ணுயிரியல் பூஞ்சைகள் மற்றும் பாக்டீரியாக்கள் இருப்பது கண்டுபிடிக்கப்பட்டுள்ளது. இந்த வகை பாக்டீரியாக்கள் பூமியில் ஜிம், பொது இடம், மருத்துவமனை போன்ற இடங்களில் பெரிதும் காணப்படும் என்று தெரிவிக்கப்பட்டுள்ளது.

ஐ.எஸ்.எஸ் இல் பாக்டீரியா
கடந்த 14 மாதத்தில் மூன்று முக்கிய விண்வெளி விமானத்தில், மரபணு வரிசை முறை மற்றும் பாரம்பரிய கல்ச்சரிங் முறை போன்ற முறைகளைப் பயன்படுத்தி பாக்டீரியாக்கள் கண்டுபிடிக்கப்பட்டுள்ளது. ஐ.எஸ்.எஸ் இல் கண்டுபிடிக்கப்பட்டுள்ள அனைத்து பாக்டீரியாக்களும் மனித தொடர்புடையது என்பது குறிப்பிடத்தக்கது.

அதிர்ச்சி தகவல்
விமானத்தின் ஜன்னல், கழிப்பறை, உடற்பயிற்சி தளம், உணவளிப்பு மேடை மற்றும் படுக்கை உள்ளிட்ட ஐ.எஸ்.எஸ் இல் உள்ள எட்டு இடங்களில் சேகரிக்கப்பட்ட மேற்பரப்பு மாதிரிகள் இந்த அதிர்ச்சி தகவலைத் தெரிவித்துள்ளது.

பாக்டீரியா வகை
ஸ்டேஃபிளோகோகஸ், பான்ட்டியா மற்றும் பேசிலஸ் பாக்டீரியா போன்ற பாக்டீரியாக்கள் தான் பெரிதும் காணப்பட்டுள்ளது.

மனிதனின் இரைப்பை குடல்
இவை மனிதனின் தோல், மூக்கு துவாரம் மற்றும் மனிதனின் இரைப்பை குடல்களில் பெரிதும் காணப்படும் பாக்டீரியாக்கள் என்பது குறிப்பிடத்தக்கது.


Click it and Unblock the Notifications